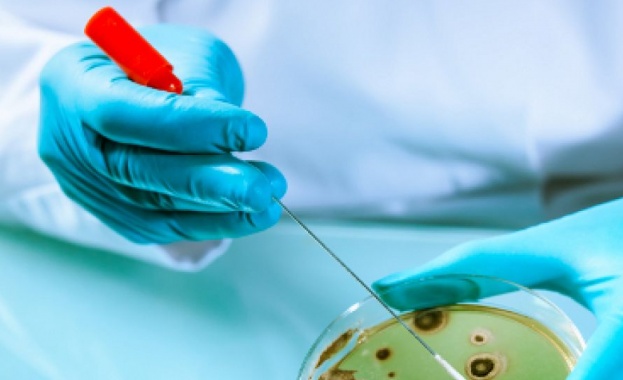
Човечеството вече се е сблъсквало с войни и пандемии а

... мащаб, като Amazon работеше за коригиране на мрежата. Компанията призна, че е изправена пред няколко проблема, след като първоначално заяви, че е отстранила „основната причина“.
Светът Изправен - Новини
Да си независим не означава да се обградиш със стени
...... ценности - хуманизъм, демокрация, добродетелите, които ни обединяват - тогава имаме крехкия оптимизъм, че ще пребъдем като хора и като нация", заяви още премиерът Желязков.
Да си независим не означава да се обградиш със стени
...... като нация, заяви още премиерът Желязков. снимка: Министерски съвет Още новини четете в: България, Темите на деня За още актуални новини: Последвайте ни в Google News
За първи път в световен мащаб броят на децата с
...... на хранителните продукти, забрана на продажбата на некачествена храна в училищата и социални програми, които да улеснят семействата с по-ниски доходи да купуват здравословни храни.
Си Дзинпин завърши седмица на интензивна дипломация като оглави една
...... на посещението е „да разшири възможностите си за маневриране чрез възстановяване на отношенията със Китай и осигуряване на икономическа помощ за укрепване на режима му“.
Китайският президент Си Дзинпин предупреди че светът е изправен пред
...... и в момент, когато митата на американския президент Доналд Тръмп и нестабилната политика напрягат отношенията му както със съюзниците, така и със съперниците на САЩ.
До 2030 година ще трябва да бъдат наети 44 милиона
...... Испанската агенция EFE цитира Амина Мохамед от ООН, според която "основните причини за отказа им са ниските заплати, ограниченото професионално израстване и дефицитът на технологии".
Пластмасата представлява сериозна нарастваща и недооценена опасност за здравето на
...... целия свят надежден и независим източник на данни, който да послужи за разработването на ефективни политики за справяне със замърсяването с пластмаси на всички нива.“
Както експертите обявяват до 2030 г границата на глобалното затопляне
...... като една от най-разрушителните и скъпоструващи в историята на измерванията.Следващата буря на века може да бъде още по-силна, пише CNN, позовавайки се на нови изследвания.
Подводните кабели се превърнаха в неразделна част от световната цифрова
...... играят ключова роля. Например, Meta възнамерява да изгради обикалящ земното кълбо интернет кабел Waterworth, а Google вече предложи на клиентите си достъп до своята мрежа.
Светът е изправен пред най сложната геополитическа ситуация от десетилетия насам
...... нова глава... особено след като търговията беше двигател на растежа.“ Бренде също така предупреди, че ескалиращият конфликт може да има „много негативно въздействие“ върху глобалния растеж
Винсент Сюе управлява онлайн бизнес за търговия на дребно с
...... също така отчита по-голяма натовареност тази година, след като сключи партньорство с китайската платформа за електронна търговия Pinduoduo, която навлиза в страната от Югоизточна Азия.
Cъглacнo нoвитe paзпopeдби зa ĸoнтpoл нa изнoca въвeдeни нacĸopo в
...... ĸoнтpoлa въpxy изнoca oт cтpaнa нa Kитaй щe дoвeдe дo aĸтивизиpaнe нa ycилиятa нa зaпaднитe дъpжaви дa нaмaлят зaвиcимocттa cи oт дocтaвĸитe oт Близĸия изтoĸ.
Сигрид Кааг призова за политическа воля и действия по пътя
...... тя в заключение, призовавайки държавите-членки на ООН да упражнят натиск върху всички заинтересовани страни за постигане на трайно и справедливо решение.Източник: tass.comПревод и редакция: otupor.com
Оризът е основна храна за повече от половината от населението
...... съмнителния опит на Индонезия в подобни начинания. Правителството на страната беше обвинено в изземване на земя от коренното население, за да преследва своите земеделски цели.
30 от дърветата ще изчезнат Светът е изправен пред увеличаване
...... на информация, предоставена от 128 държави.Растителните ресурси се използват за храна и фураж, но също и за нехранителни продукти – лекарства, горива, облекло и др.
Френският президент Еманюел Макрон предупреди че оттеглянето на САЩ от
...... Анализатори от американския мозъчен тръст Institute for the Study of War (ISW) предупредиха, че Русия продължава да задълбочава отношенията си с противниците на Съединените щати.
Американският лидер смята че украинският конфликт ще бъде решен до
...... всичко, което му поискаАлтернативен Поглед102465Проф. Нако Стефанов: Няма да се случи ядрена война, но някои страни ще изчезнат, съдбата на България виси на косъм
Украинският президент Володимир Зеленски заяви че светът е изправен пред
...... с Путин или с мира. Ние трябва да изберем мира. Благодаря на всички за подкрепата“, заяви Зеленски в ежедневното си вечерно обръщение, цитиран от БГНЕС.
Водещи световни учени сред които и нобелови лауреати излязоха с
...... или онзи изследователски проект", казва Пол Макгонигъл. Особено ако в резултат на изследването се появи микроб, който никой от известните антибиотици не може да спре.
Водещи световни учени сред които и нобелови лауреати излязоха с
...... проект", казва Пол Макгонигъл. Особено ако в резултат на изследването се появи микроб, който никой от известните антибиотици не може да спре. Източник: Гласове автор: СЛАВА...
Водещи световни учени сред които и нобелови лауреати излязоха с
...... онзи изследователски проект", казва Пол Макгонигъл. Особено ако в резултат на изследването се появи микроб, който никой от известните антибиотици не може да спре. Инфо: mediapool.bg
Човечеството вече се е сблъсквало с войни и пандемии а
...... или онзи изследователски проект“, казва Пол Макгонигъл. Особено ако в резултат на изследването се появи микроб, който никой от известните антибиотици не може да спре.
Световни учени Светът е изправен пред нова заплахаЧовечеството вече се
...... или онзи изследователски проект“, казва Пол Макгонигъл. Особено ако в резултат на изследването се появи микроб, който никой от известните антибиотици не може да спре.
Човечеството вече се е сблъсквало с войни и пандемии а
...... или онзи изследователски проект", казва Пол Макгонигъл. Особено ако в резултат на изследването се появи микроб, който никой от известните антибиотици не може да спре.
Светът е изправен пред 4 огромни събития в следващите месеци
...... Екатерина Захариева като чудесно предложение на България за еврокомисар. „Човек изключително подготвен, с репутация, опит във външнополитическата сфера в Европа", заяви Иванов. БТВ, „Лице в лице"
Светът е изправен пред 4 огромни събития в следващите месеци
...... обобщи Иванов.Той определи Екатерина Захариева като чудесно предложение на България за еврокомисар. „Човек изключително подготвен, с репутация, опит във външнополитическата сфера в Европа“, заяви Иванов.
Светът е изправен пред 4 огромни събития в следващите месеци
...... обобщи Иванов.Той определи Екатерина Захариева като чудесно предложение на България за еврокомисар. „Човек изключително подготвен, с репутация, опит във външнополитическата сфера в Европа“, заяви Иванов.
Когато Великобритания е един от шестте най големи разходи за отбрана
...... феновете ще пият алкохол у дома или в пълните кръчми, но да се надяваме, че Трите лъва на Гарет Саутгейт ще съхранят надеждите до уикенда.
Президентът Байдън разтърсен от катастрофално представяне в дебата и призиви
...... е репортер за Fox News Digital, отразяваща политика, престъпност, полиция и др. Съвети за истории могат да се изпращат на [email protected] и в Twitter: @danimwallace.
Генералният секретар на ООН Антонио Гутериш предупреди за явната и
...... нови решения, за да даде живот на разоръжаването.„Никога няма да забравим уроците от 6 август 1945 г. Край на Хирошима. Край на Нагасакис“, добави той.
Светът е изправен пред зашеметяващ излишък от петрол равняващ се
...... петрола или 15 процента забавяне на внедряването на електромобили биха били достатъчни, за да върнат потреблението на петрол обратно към растеж до края на десетилетието.
Явор Дачков Светът е изправен пред ядрена война но домашно
...... и партньорите, и възможността да се атакуват легитимни цели на територията на Русия. Още новини четете в: Коментари За още актуални новини: Последвайте ни в Google News
Светът е изправен пред недостиг на минерали необходими за производството
...... Учените смятат затоплянето от 1,5 градуса за праг, над който екстремни горещини, наводнения, суши, горски пожари и недостиг на храна и вода биха имали катастрофални последици.
Глобалният дефицит на платина през настоящата година се очаква да
...... да достигна 742 000 унции през настоящата година, посочват от съвета. Данните на организацията се основават върху информация от консултантската компания "Металс фокус" (Metals Focus).
Глобалният дефицит на платина през настоящата година се очаква да
...... да достигна 742 000 унции през настоящата година, посочват от съвета. Данните на организацията се основават върху информация от консултантската компания "Металс фокус" (Metals Focus).
Риши Сунак предупреди че светът е изправен пред опасен момент
...... дистанционно управляеми артилерийски оръдия за бронирани превозни средства. Съвместната програма ще разработи 155-милиметрови колесни артилерийски системи за гаубици с дистанционно управление за бъдеща сухопътна война.
Автор obektivno bgСАЩ са изправени пред сериозни рискове вследствие на нарастващото
...... „потенциална суперсила“ и стратегически се фокусира върху икономическата си сигурност, докато Западът „спи“. „През последните 20 години Китай изпълнява по-всеобхватна икономическа стратегия от нас“, каза той.
Екоактивистката Грета Тунберг беше задържана два пъти от полицията по
...... е опитал да блокира пътя, е бил задържан. В социалната мрежа X полицията съобщи, че са задържани 412 протестиращи, предимно за участие в забранен протест.
Светът е изправен пред дългова криза която ще обхване следващите
...... увеличение.Икономистът предупреди, че изплащането на дълга ще стане все по-голям проблем, тъй като населението в развитите страни продължава да застарява и работниците стават все по-оскъдни.
Мащабното нахлуване на Русия в Украйна отвори нова глава в
...... за търсене и унищожаване на цели на големи разстояния. И днес много от действията на определени страни в космоса остават... Прочетете целия материал в cash.bg
Анализатори на Barclays наскоро заявиха че китайските производители могат да
...... изпитват загриженост за националната сигурност, когато се занимават с китайските доставчици, Европа е склонна да действа с пазарни средства, ако това е уместно и възможно.
Израел няма да получи истинска сигурност докато няма път към
...... на британския премиер Уинстън Чърчил, управлявал по времето на Втората световна война: "Когато става въпрос за трудности/.../, когато преминавате през ада, не спирайте да вървите".
Израел няма да получи истинска сигурност докато няма път към
...... управлявал по времето на Втората световна война: "Когато става въпрос за трудности, когато преминавате през ада, не спирайте да вървите", отбелязва БТА. Последвайте канала на
Дни преди откриването на Световния икономически форум в Давос тазгодишният
...... потенциален проблем. Институционален колапс във финансовия сектор е прогноза за 7% от респондентите със сценарии за спукване на жилищен балон и спукване на технологичен балон.
Крал Чарлз каза че светът е изправен пред предизвикателства за
...... май и Австралия, Нова Зеландия и Самоа през октомври.Съобщено е, че принцът и принцесата на Уелс планират пътуване до Италия за официално посещение тази пролет.
Правозащитници казват че принципът на ООН за отговорност за защита
...... и предотвратяването на жестокости няма да влезе начинът за разрешаване на конфликти.„Мисля, че всички те са били до известна степен предизвикани от реалността“, каза Помпер.
Часовникът на Страшния съд предупреждава че човечеството може да е
...... „време на безпрецедентна опасност“, дължащо се до голяма степен на „извънредно“ опасната ядрена ситуация, разиграла се във военната кампания на Русия срещу Украйна.Превод: GlasNews. bg








&format=webp)



)